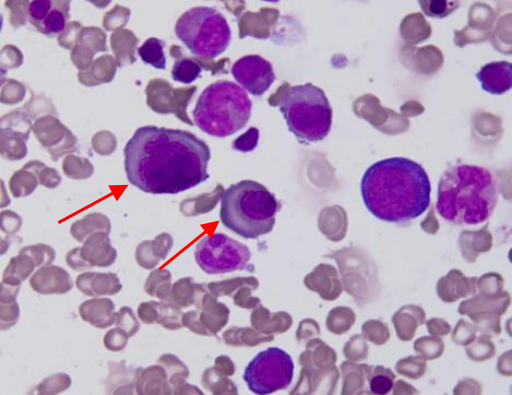

【第一百二十期】基层检验网形态学培训
每周一次,每次几张,只要您坚持来,抽出几分钟的时间,相信您的识图能力会不知不觉的提升哦
患者,男,59 岁,乏力、活动后心悸半年,加重伴腹痛半月伴食欲明显减退,入院后胃
镜提示“胃多发溃疡、糜烂性胃炎”,腹部 CT 提示“阑尾炎”。血常规 WBC 2.81×10^9/L,
RBC 1.30×10^12/L,Hb 57 g/L, PLT 129×10^9/L。骨髓涂片如下
1、请写出图中箭头所指细胞名称(骨髓,瑞氏染色,10x100):
答案:巨杆状核中性粒细胞
解析:胞体较大,直径可在 20um 左右,类圆形,胞质较多,含有丰富粉红色中性颗粒,核染色质疏松,细胞核呈杆状、肿胀。
2、请写出图中箭头所指细胞名称(骨髓,瑞氏染色,10x100):

答案:巨多分叶核中性粒细胞
解析:胞体较大,类圆形,直径约 16-25um,胞浆丰富,含有大量粉红色中性颗粒,核染色质聚集成块状,胞核常分 6 叶以上。
3、请写出图中箭头所指细胞名称(骨髓,瑞氏染色,10x100):
答案:巨中幼红细胞
解析:胞体较大,直径 10-20um,核染色质聚集成细块,但较正常中幼红细致,有颗粒感,副染色质明显,呈粗略的网状。胞质丰富,呈多色性或淡灰色,胞核与胞质发育不平衡,胞核发育落后于胞质,呈“核幼浆老“改变。
4、请写出图中箭头所指细胞名称(骨髓,瑞氏染色,10x100):
答案:巨晚幼红细胞
解析:胞体较大,直径 10-18um,胞核较小,常偏位,核形可不规则,核染色质聚集成块状,但仍保留网状结构痕迹。胞质丰富,因含丰富的血红蛋白,呈红色或灰红色,胞核发育落后于胞质,呈“核幼浆老“改变。
5、结合患者骨髓细胞形态特点,推测该患者最可能的诊断为:
答案:巨幼细胞贫血
解析:巨幼细胞贫血是临床上最常见的贫血之一,是由于叶酸、维生素 B12 缺乏或某些药物影响核苷酸代谢,导致细胞核脱氧核糖核酸代谢障碍,引起的大细胞性贫血。此病人叶酸19.12nmol/L(参考范围 8.83-60.8nmol/L) ,维生素 B12 36.9pmol/L(参考范围 145.38-569pmol/L),维生素 B12 缺乏。血象呈大细胞性贫血,红细胞大小不等,中心淡然区消失,中性粒细胞核分叶过多。骨髓象有核细胞增生活跃或明显活跃,三系细胞巨幼变,以红系最为显著,巨幼红细胞比同期阶段正常幼红细胞体积大,胞质量丰富,核染色质呈细颗粒网状,可见核形不规则、核碎裂等,细胞核发育落后于细胞质,呈“核幼浆老”改变。粒系略增生或正常,巨晚幼粒和巨杆状核粒细胞多见,可见胞体大、分叶过多的分叶核粒细胞,骨髓象出现粒细胞巨幼变对疾病的早期诊断更有价值。巨核细胞数量正常或减少,可见巨幼变,胞体巨大,核染色质疏松,核分叶过多,核丝断裂,胞质内颗粒减少,血小板生成减少。
免责声明:基层检验网订阅号是一个提供学习讨论、资讯阅读、交流分享为一体的网络公益平台,不涉及商业盈利目的。如涉及版权问题,请联系我们予以删除。
感谢:重医大附一院检验科及綦江区检验质控中心
提供的内容。